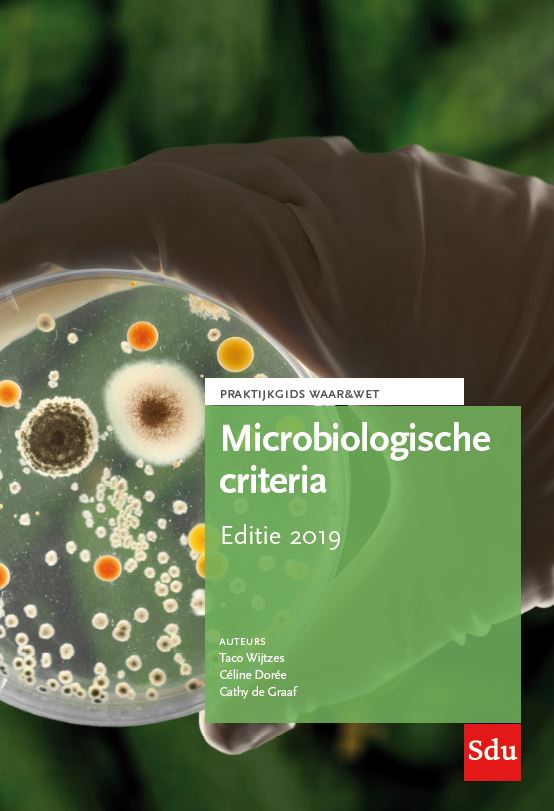

Juridisch
- Handvatten voor het opheffen van conservatoir beslag
Voor Handvatten voor het opheffen van conservatoir beslag onderzocht de auteur in het kader van haar afstuderen 1.071 op rechtspraak.nl gepubliceerde opheffingsuitspraken waaruit 75 handvatten zijn gedestilleerd die een duwtje in de rug kunnen geven voor opheffing of juist handhaving van het beslag bij de civiele rechter in kort geding.
Lees verder- |
- 2 nov. 2016
- |
- Bestelcode 9789012398985
€ 62,31 € 67,92 - Arbitrage
Arbitrage is een wereldwijd en in Nederland erkend en gewaardeerd alternatief voor geschilbeslechting door de rechter. Arbitrageprocedures worden gekenmerkt door de vrijheid van de partijen bij de keuze van de arbiters en bij de vaststelling van de regels van de procedure.
Lees verder- |
- 10 dec. 2018
- |
- Bestelcode 9789012401203
€ 61,72 € 67,27 - Vraagbaak Psychiatrie en recht
De Vraagbaak Psychiatrie en recht beschrijft de meest gestelde juridische vragen en antwoorden in de ggz. Het is een bundeling van alledaagse vragen met de bijbehorende antwoorden uit de praktijk. Hierdoor is de vraagbaak goed bruikbaar voor patiënten en hulpverleners die vragen hebben over rechten en plichten gedurende of voorafgaand aan de behandeling of ondersteuning.
Lees verder- |
- 6 dec. 2017
- |
- Bestelcode 9789012401302
€ 68,23 € 74,37 - Jaarboek Regelingen Uitvaartwezen 2018
Deze Compact-uitgave handelt over de Wet op de lijkbezorging en aanverwante onderwerpen. Het boek is bestemd voor diegenen die in de dagelijkse praktijk werkzaam zijn op het gebied van de uitvaartverzorging en de daarmee samenhangende onderwerpen. Getracht is op een duidelijke wijze de wet en de daaruit voortvloeiende procedures en werkwijzen te beschrijven.
Lees verder- |
- 16 mrt. 2018
- |
- Bestelcode 9789012401456
€ 98,63 € 107,51 - Terugdringen van psychisch lijden van ouders en kinderen bij scheiding
Scheidingsbegeleiding zou gericht moeten zijn op het minimaliseren van psychisch lijden en het vergroten van de effectiviteit van ouders, kinderen en professionals.
Lees verder- |
- 25 jun. 2019
- |
- Bestelcode 9789012404716
€ 63,25 € 68,94 - Kind en scheiding, Monografieën (echt)scheidingsrecht deel 8.
In Kind en scheiding worden de schijnwerpers gericht op de juridische gevolgen van echtscheiding in relatie tot de kinderen. Door invoering op 1 maart 2009 van de Wet bevordering voortgezet ouderschap en zorgvuldige scheiding is het echtscheidingsrecht ook wat de rechtspositie van ouders en kinderen betreft ingrijpend gewijzigd.
Lees verder- |
- 18 apr. 2019
- |
- Bestelcode 9789012404327
€ 66,53 € 72,52 - Aanbestedingsrecht voor overheden
Aanbestedingsrecht voor overheden is bedoeld voor de vele juristen, adviseurs van aanbesteders en ondernemers die in de praktijk met aanbestedingen werken. In deze geheel herziene vijfde druk wordt op praktische en overzichtelijke wijze het Nederlandse en Europese aanbestedingsrecht behandeld.
Lees verder- |
- 3 jul. 2017
- |
- Bestelcode 9789035248038
€ 93,09 € 101,47 - E-nieuws Regelingen Onderwijs VO
Met E-nieuws Regelingen Onderwijs VO ben je altijd up-to-date. Het biedt je letterlijk de regelingen zoals deze zijn gepubliceerd, met daarbij een heldere toelichting van een onafhankelijke deskundige. Dit e-nieuws is makkelijk én overzichtelijk!
Lees verder- |
- Bestelcode EGKVO
€ 96,00 Vanaf € 104,64 - E-nieuws Regelingen Onderwijs PO
Met E-nieuws Regelingen Onderwijs PO ben je altijd up-to-date. Het biedt je letterlijk de regelingen zoals deze zijn gepubliceerd, met daarbij een heldere toelichting van een onafhankelijke deskundige. Dit e-nieuws is makkelijk én overzichtelijk!
Lees verder- |
- Bestelcode EGKPO
€ 96,00 Vanaf € 104,64 - E-nieuws Regelingen Onderwijs HO
Met E-nieuws Regelingen Onderwijs HO ben je altijd up-to-date. Het biedt je letterlijk de regelingen zoals deze zijn gepubliceerd, met daarbij een heldere toelichting van een onafhankelijke deskundige. Dit e-nieuws is makkelijk én overzichtelijk!
Lees verder- |
- Bestelcode EGKHO
€ 96,00 Vanaf € 104,64 - E-nieuws Regelingen Onderwijs BVE
Met E-nieuws Regelingen Onderwijs BVE ben je altijd up-to-date. Het biedt je letterlijk de regelingen zoals deze zijn gepubliceerd, met daarbij een heldere toelichting van een onafhankelijke deskundige. Dit e-nieuws is makkelijk én overzichtelijk!
Lees verder- |
- Bestelcode EGKBVE
€ 96,00 Vanaf € 104,64 - Regelingen Onderwijs (tijdschrift + online + app)
Het tijdschrift Regelingen Onderwijs verschijnt 11x per jaar en informeert u over alle wet- en regelgeving in het onderwijs.
Lees verder- |
- Bestelcode UITLEGREG
€ 197,00 Vanaf € 214,73 - Blockchain en smart contracts
Dit boek is de eerste Nederlandstalige monografie die u een overzicht biedt van de juridische, technische en maatschappelijke aspecten van blockchain en smart contracts. Door de intensieve, interdisciplinaire samenwerking tussen een publiekrechtelijke jurist, een computerwetenschapper/ cryptograaf en een privaatrechtelijke jurist/ingenieur informatica is een uniek boek ontstaan dat u op een overzichtelijke, wetenschappelijk onderbouwde en toegankelijke wijze op de hoogte brengt van de uitdagingen, mogelijkheden en beperkingen van deze technologie.
Lees verder- |
- 30 apr. 2020
- |
- Bestelcode 9789012405850
€ 52,59 € 57,32 - Alimentatieverplichtingen. Editie 2020
In dit onderdeel wordt ingegaan op de rechtsgrond voor alimentatie, de onderhoudsplichtigen en onderhoudsgerechtigden, de maatstaven draagkracht en behoefte, wijziging en limitering. Ook het afwijkende procesrecht komt aan de orde.
Lees verder- |
- 30 apr. 2020
- |
- Bestelcode 9789012404273
€ 66,53 € 72,52 - Tuchtrecht en de kwaliteit van het professioneel handelen
De bundel Tuchtrecht en de kwaliteit van het professioneel handelen is de weerslag van 'invitational conference' aan de Universiteit Utrecht binnen het focusgebied professional performance in november 2018. Deze conferentie werd georganiseerd naar aanleiding van de vraag of de kwaliteit van het medisch handelen ook repressief verbeterd kan worden via het tuchtrecht.
Lees verder- |
- 23 sep. 2019
- |
- Bestelcode 9789012405348
€ 31,01 € 33,80 - Medische hulpmiddelen: eindelijk goed geregeld?
In dit Preadvies 2020 staat de volgende vraag centraal: is de regulering van medische hulpmiddelen eindelijk goed geregeld?
Lees verder- |
- 18 mrt. 2020
- |
- Bestelcode 9789012405393
€ 55,83 € 60,85 - Microbiologische criteria. Editie 2019
Voedingsmiddelen moeten veilig zijn en van goede kwaliteit. Een van de belangrijkste parameters voor veilig voedsel is de microbiologische gesteldheid van het product. Levensmiddelen mogen geen schadelijke micro-organismen bevatten in hoeveelheden die een onaanvaardbaar risico voor de menselijke gezondheid vormen. Grenswaarden worden vaak vastgelegd in de vorm van criteria. In deze praktijkgids vind je tabellen waarin wordt weergegeven welke criteria er zijn voor diverse micro-organismen en voor welke voedingsmiddelen deze criteria gelden.
Lees verder- |
- 24 okt. 2019
- |
- Bestelcode 9789012404853
€ 99,58 € 108,54 - De AVG toegelicht voor verenigingen en stichtingen
De Algemene Verordening Gegevensbescherming is met veel publicitaire aandacht en campagnes vanuit de overheid op 25 mei 2018 in werking getreden. Ook non-profitorganisaties, zoals muziekverenigingen, kerkelijke genootschappen, andere organisaties op levensbeschouwelijke grondslag, politieke partijen en amateursportverenigingen hebben hiermee te maken, maar een goede ondersteuning hiervoor ontbreekt vaak. De AVG toegelicht voor verenigingen en stichtingen is speciaal voor de bestuurders van non-profitorganisaties en bevat een handzame, praktische uiteenzetting van de nieuwe wetgeving in toegankelijke taal.
Lees verder- |
- 14 nov. 2019
- |
- Bestelcode 9789012405300
€ 37,15 € 40,49 - Juridische splitsing van kapitaalvennootschappen
Deze uitgave besteedt aandacht aan de civiel- en fiscaalrechtelijke aspecten van juridische splitsingen. Het accent ligt daarbij op kapitaalvennootschappen.
Lees verder- |
- 22 aug. 2019
- |
- Bestelcode 9789012404945
€ 83,12 € 90,60 - VIND Tender Nieuwsbrief Online
De Tender Nieuwsbrief Online behandelt visies, achtergronden en actuele ontwikkelingen rond het thema Europees aanbesteden. Eén van de uitgangspunten van de Tender Nieuwsbrief Online is om een brug te slaan tussen de vraag-en aanbodzijde van de aanbestedingsmarkt.
Lees verder- |
- Bestelcode VINDTENOL
€ 308,00 Vanaf € 335,72 - Tien jaar conclusies in het bestuursrecht
Een bundeling van acht geselecteerde conclusies in het bestuursrecht die stuk voor stuk algemene bestuursrechtelijke leerstukken bespreken en van nut zijn (gebleken) in de rechtspraktijk.
Lees verder- |
- 16 dec. 2022
- |
- Bestelcode 9789012408288
€ 97,01 € 105,74 - Aanbestedingswet 2012. Editie 2021. Tekst en Toelichting.
Deze editie van Tekst & Toelichting Aanbestedingswet 2012 is een alomvattende kennisbron van grote praktische waarde. Het boek geeft een compleet en actueel beeld van het Nederlandse aanbestedingsrecht anno 2021 en is daarmee een onmisbare uitgave voor een ieder die regelmatig met aanbestedingen te maken heeft! Ook het gespecialiseerde hoger onderwijs maakt volop gebruik van deze uitgebreide kennisbron.
Lees verder- |
- 4 aug. 2021
- |
- Bestelcode 9789012406840
€ 143,02 € 155,89 - Vijftig jaar kostenbeheersing in de zorg. Deel II: 1995-2020
Kostenbeheersing is al vele decennia een centraal thema in de geschiedenis van de gezondheidszorg en de collectieve lasten. De auteurs gaan in een tweeluik in op de vraag hoe het kostenbeheersingsbeleid in de jaren 1966-2020 werd ontwikkeld onder invloed van de politieke en maatschappelijke visies. Dit boek is het tweede deel van dit tweeluik.
Lees verder- |
- 1 nov. 2021
- |
- Bestelcode 9789012401647
€ 57,29 € 62,45 - Compendium Levenstestament
In het Compendium Levenstestament worden de verschillende aspecten die aan het levenstestament verbonden zijn op een gestructureerde en begrijpelijke wijze behandeld. Zo worden de wettelijke beschermingsmaatregelen verkend en afgezet tegen het levenstestament, wordt het normaaltype van het levenstestament behandeld en wordt uitgebreid stilgestaan bij de rechtsverhouding tussen de levenstestateur en de levensexecuteur.
Lees verder- |
- 8 dec. 2021
- |
- Bestelcode 9789012406475
€ 68,92 € 75,12 - Compendium Erfprocesrecht
Het Compendium Erfprocesrecht behandelt een breed scala aan onderwerpen op het gebied van het erfprocesrecht. Redactie én auteurs zijn werkzaam in het notariaat, de advocatuur, de wetenschap en bij de rechterlijke macht.
Lees verder- |
- 24 dec. 2021
- |
- Bestelcode 9789012406451
€ 91,84 € 100,11

iDeal